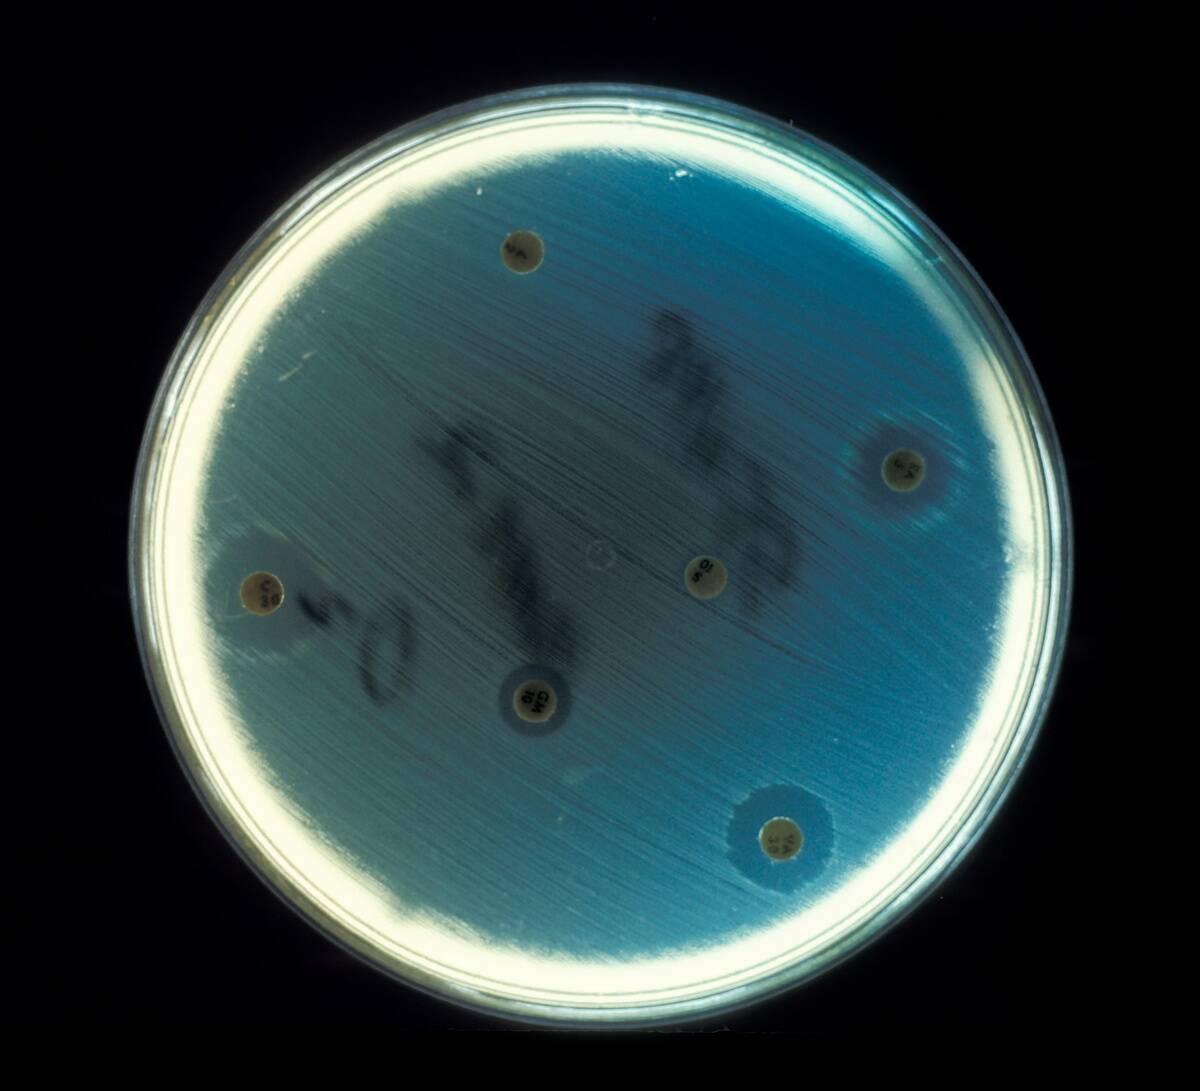
Enterococcus Faecalis
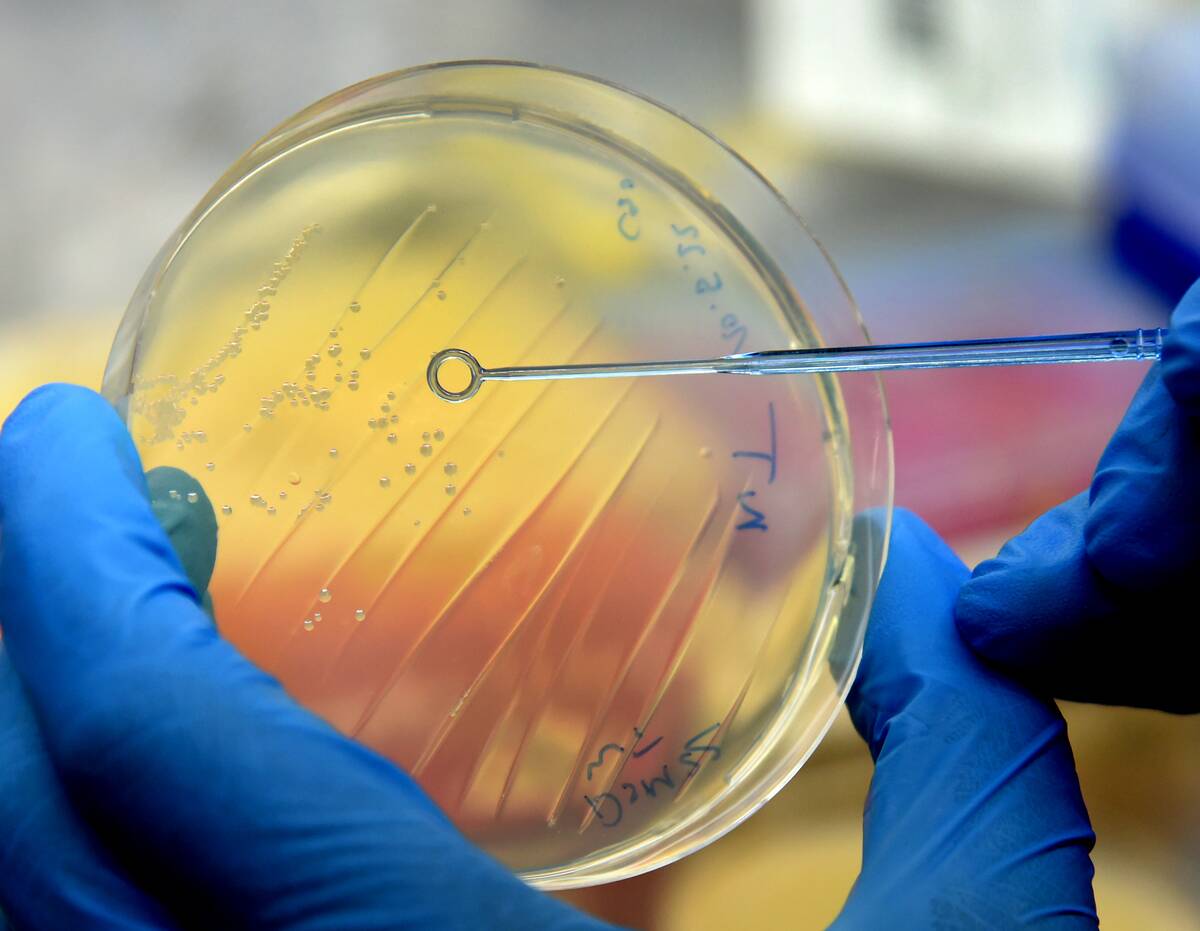
Newly discovered enzyme decomposes PET plastic much faster

Microbes powering industrial processes
Trending Now
Welcome to the fascinating world of microbes, where these microscopic organisms wield immense power. Despite their size, microbes play an integral role in various industries, contributing to everything from energy production to environmental cleanup.
They are nature’s multitaskers, capable of performing complex chemical reactions that humans can only dream of emulating. As we delve deeper, you’ll discover the incredible versatility of these tiny titans and their pivotal contributions to modern industry.
A Brief History of Microbial Utilization

The use of microbes dates back thousands of years, even though we only discovered their existence a few centuries ago. Ancient civilizations unknowingly harnessed their power in processes like fermentation, creating bread and beer.
It wasn’t until the 17th century that Antonie van Leeuwenhoek first observed them under a microscope. Fast forward to the 20th century, and we see the rise of industrial microbiology, where microbes began to be used in a controlled manner to produce antibiotics, vitamins, and enzymes.
Understanding Microbes: What Are They?
Microbes, or microorganisms, encompass bacteria, fungi, viruses, and protozoa, among others. Despite their simple structures, they are incredibly diverse and can be found in almost every environment on Earth.
Bacteria, for example, can thrive in extreme conditions, from the scalding heat of hydrothermal vents to the icy depths of Antarctica. This adaptability makes them invaluable to numerous industries, as they can be engineered to perform specific tasks tailored to industrial needs.
The Role of Microbes in Natural Processes

Microbes are the unsung heroes of many natural processes, playing crucial roles in nutrient cycling and decomposition. In the nitrogen cycle, for instance, bacteria convert nitrogen gas from the atmosphere into forms that plants can use.
Similarly, decomposer microbes break down dead organic matter, recycling nutrients back into ecosystems. These natural processes highlight the importance of microbes in maintaining ecological balance and supporting life on Earth.
Microbes in Waste Management: Nature’s Recyclers

In the realm of waste management, microbes act as nature’s recyclers, breaking down organic materials in landfills and wastewater treatment plants. Certain bacteria can digest pollutants and hazardous substances, transforming them into less harmful compounds.
This biodegradation process not only reduces the volume of waste but also minimizes its environmental impact. By harnessing these natural capabilities, industries are developing more sustainable waste management solutions, turning to microbes to tackle pollution.
Biofuels: How Microbes Are Energizing Our Future

Microbes are at the heart of biofuel production, offering a renewable energy source that could replace fossil fuels. Algae, for instance, can produce lipids that are converted into biodiesel, while certain bacteria ferment sugars to produce bioethanol.
This microbial approach to energy production is not only sustainable but also reduces greenhouse gas emissions. As research advances, we continue to unlock the potential of microbes to power a greener, more energy-efficient future.
Microbes in the Food Industry: Fermentation and Beyond

The food industry has long relied on microbes for fermentation, a process that enhances flavor and preserves food. Yeast, for example, is vital in baking and brewing, while lactic acid bacteria are key to producing yogurt and cheese.
Beyond fermentation, microbes are also used in food safety, as they can inhibit the growth of harmful pathogens. As our understanding of microbial processes expands, we’re discovering new ways to enhance food production and safety.
The Science of Microbial Mining: Extracting Metals with Bacteria

Microbial mining, or biomining, uses bacteria to extract metals from ores, a process that is more environmentally friendly than traditional mining methods. For instance, the bacterium Acidithiobacillus ferrooxidans can leach copper from sulfide ores.
This technique not only reduces the need for harsh chemicals but also minimizes the environmental footprint of mining operations. As the demand for sustainable practices grows, biomining offers a promising alternative for metal extraction.
Microbes in Pharmaceuticals: Tiny Doctors at Work

In the pharmaceutical industry, microbes are invaluable for producing antibiotics, vaccines, and other medications. Penicillin, the first widely used antibiotic, is derived from the mold Penicillium. Additionally, genetically engineered bacteria produce insulin for diabetes treatment.
These tiny doctors are at the forefront of medical advances, offering innovative solutions to health challenges. As biotechnology evolves, microbes will continue to play a crucial role in developing new therapies and drugs.
How Microbes Are Revolutionizing Agriculture

Microbes are transforming agriculture by promoting plant growth and protecting crops from pests. Beneficial bacteria and fungi, known as biofertilizers, enhance soil fertility and improve nutrient uptake.
Meanwhile, biopesticides derived from microbes offer a natural alternative to chemical pesticides, reducing environmental impact. As the agricultural sector seeks sustainable practices, the use of microbial solutions is becoming increasingly prevalent, paving the way for eco-friendly farming.
The Role of Microbes in Textile Manufacturing
In textile manufacturing, microbes offer innovative solutions for producing and treating fabrics. Enzymes derived from microbes are used in the biopolishing and bio-bleaching of textiles, enhancing texture and color without harsh chemicals.
Additionally, microbial processes can produce biodegradable fibers, reducing the environmental footprint of textile production. As the industry seeks sustainable alternatives, microbes are proving to be valuable allies in creating eco-friendly textiles.
Microbial Innovations in Environmental Cleanup

Microbes are at the forefront of bioremediation, the process of using biological agents to clean up contaminated environments. Certain bacteria can degrade oil spills, while others can neutralize heavy metals in soil and water.
This natural approach to environmental cleanup is both effective and sustainable, offering a greener solution to pollution. As we continue to face environmental challenges, microbial innovations are key to restoring ecosystems and protecting natural resources.
The Future of Construction: Microbial Building Materials

Microbes are paving the way for sustainable construction materials, with innovations like self-healing concrete and bio-bricks. Bacteria such as Bacillus can precipitate calcium carbonate, repairing cracks in concrete and extending its lifespan. Meanwhile, bio-bricks made from microbial processes offer an eco-friendly alternative to traditional bricks.
These innovations not only reduce construction waste but also lower the carbon footprint of building projects, highlighting the potential of microbes in the future of construction.
Harnessing Microbes for Renewable Energy Production

Microbes are key players in the quest for renewable energy, contributing to biohydrogen and biogas production. Certain bacteria can produce hydrogen gas through fermentation, while methanogenic archaea generate methane in anaerobic digesters.
These microbial processes offer sustainable energy solutions, reducing reliance on fossil fuels and decreasing greenhouse gas emissions. As research advances, the potential for microbes to revolutionize energy production continues to grow, promising a cleaner, greener future.
Microbes in Cosmetics: Beauty Secrets from the Microscopic World

In the cosmetics industry, microbes are becoming beauty’s best-kept secret, revolutionizing skincare and personal care products. Probiotics and postbiotics derived from beneficial bacteria are used to balance the skin’s microbiome, promoting healthy, radiant skin.
Additionally, microbial enzymes are employed in formulations to enhance product efficacy and texture. As consumers seek natural and effective beauty solutions, microbes are playing an increasingly important role, offering innovative and sustainable approaches to skincare.
The Ethical Considerations of Industrial Microbiology

As we harness the power of microbes, ethical considerations must be taken into account. Issues such as biosecurity, environmental impact, and the potential for unintended consequences require careful regulation and oversight.
Ensuring that microbial technologies are used responsibly is crucial to maintaining ecological balance and public safety. As the field of industrial microbiology continues to evolve, ongoing discussions about ethical practices will play a vital role in shaping its future.
Microbial Engineering: Designing the Workers of Tomorrow

Microbial engineering is at the forefront of biotechnology, where scientists design and modify microbes to perform specific tasks. Through genetic engineering, microbes can be tailored to produce biofuels, pharmaceuticals, and other valuable products.
This innovative approach allows for precision and efficiency in industrial processes, opening up new possibilities for sustainable production. As we look to the future, microbial engineering holds the promise of designing the workers of tomorrow, capable of addressing global challenges.
The Challenges and Risks of Harnessing Microbes

While the potential of microbes is immense, harnessing them comes with challenges and risks. Issues such as antibiotic resistance, biosecurity threats, and the release of genetically modified organisms into the environment must be carefully managed.
Additionally, the complexity of microbial communities presents difficulties in controlling and predicting their behavior. Addressing these challenges requires robust regulatory frameworks and ongoing research to ensure the safe and responsible use of microbial technologies.




